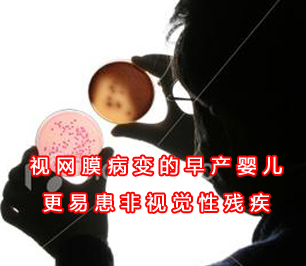

发表在《美国医学会杂志》上的一则研究披露,在一组出生体重极低的婴儿中,早产所致的严重视网膜病变与他们在5岁时的非视觉性残疾相关。
早产儿的严重视网膜病变(视网膜疾病)会在接受过高浓度氧气治疗的早产婴儿中发生,它是早产儿在新生儿重症监护过程中出现的一个严重的并发症。根据文章的背景资料:“尽管严重视网膜病变的发生率自1980年代晚期以来一直在增加,但在发达国家中,由视网膜病变所引起的失明已经变得不多见了。因此,临床医生及孩子的父母可能会得出结论,认为严重视网膜病变已经不再与童年时的功能损害有关。”
费城儿童医院的BarbaraSchmidt,M.D.,M.Sc.及其同事对患有严重视网膜病变的婴儿与那些没有严重视网膜病变的婴儿相比是否会持续面临非视觉性残障风险的增加进行了调查。这一分析(所用的数据来自一个叫做用咖啡因治疗早产儿呼吸暂停的试验)包括了出生体重在1.1至2.8磅的婴儿,他们是在1999至2004年间出生的,他们被随访至5岁(2005-2011)。
在1815名符合条件的婴儿中,有1582人(87%)有着完整的(n=1523)或部分的(n=59)的为期5年的评估。在95名患有严重视网膜病变的人中,有40%的人在5岁时至少患有1种非视觉性的残疾,而与其相比较的没有严重视网膜病变的人中,该百分比为16%。在有严重视网膜病变的95名儿童中有14人(15%)患有超过1种的非视觉性残障,而在没有严重视网膜病变的1487名儿童中有36人(2.4%)患有超过1种的非视觉性残障。患有严重视网膜病变的孩子的运动功能损害、认知功能损害及严重听力丧失要比那些没有严重视网膜病变的孩子多3-4倍。
文章的作者写道,这些发现可帮助改善向孩子父母提供咨询以及遴选高危婴儿进行长期随访的能力。
“早产儿严重视网膜病变仍然是新生儿重症监护的一个不良后果,它对孩子的发育有着不良的预后,尽管失明已大多能够通过及时的视网膜治疗而得以预防。” |